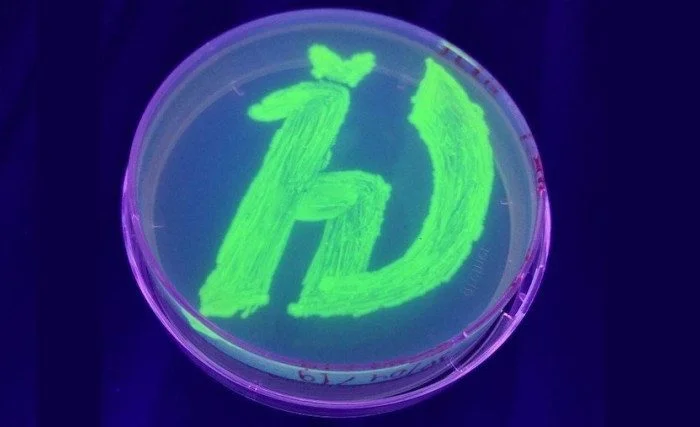
Революция в микроскопии: создан уникальный светящийся белок

Революция в микроскопии: создан уникальный светящийся белок
html Копировать Скачать Запустить
Представьте себе: мы можем подсмотреть за самыми сокровенными тайнами живой клетки, не убивая её. Звучит как фантастика, но именно это уже десятилетиями делает флуоресцентная микроскопия. А недавно учёные, в том числе из Московского физико-технического института, сделали для неё принципиально новую «подсветку». И это не просто апгрейд, а настоящий прорыв.
Всё началось в 60-х годах с зелёного флуоресцентного белка. Тогда это было чудо: удалось «заставить» светиться отдельные белки внутри живых организмов. Методы молекулярного клонирования позволили прикрепить этот «маячок» к любому интересующему нас клеточному процессу и наблюдать за ним в реальном времени. Согласитесь, здорово?
Но у классических светящихся белков есть слабые места. Они, как правило, довольно крупные и капризные: боятся жары и не работают без кислорода. А что, если нам нужно заглянуть в мир микроорганизмов, которые живут в кипятке или в бескислородной среде? Тут-то старые помощники и пасуют.
Международная команда биофизиков решила эту проблему, разработав белок, который по своим характеристикам обходит предшественников. Он не только светится под синим или ультрафиолетовым светом, но и делает это там, где другие «перегорают» или гаснут. Представьте себе миниатюрный, почти невесомый фонарик, которому не нужен воздух и который не боится температуры до 68°C.
Флуоресцентный микроскоп работает хитро: он «бьёт» по образцу мощным лазером, а специальные белки в ответ испускают свет уже с другой длиной волны. Этот отклик и превращается в изображение. Раньше мы могли изучать, как белки взаимодействуют, как распространяется инфекция или развиваются органы. Но теперь разрешение метода поднялось до наноуровня — недаром за это вручили Нобелевскую премию по химии в 2014 году. И новый белок здесь — настоящая звезда.
Термостабильный флуоресцентный белок на основе флавина
Откуда же взялся этот супергерой? Его нашли в клетках термофилов — бактерий, которые прекрасно себя чувствуют при температурах от 41 до 122°C. Сама природа подсказала решение! Учёные выделили ген, отвечающий за флуоресцентную часть белка, и аккуратно «отрезали» всё лишнее, чтобы молекула осталась миниатюрной. Никаких лишних деталей — только самое нужное.

Затем этот модернизированный ген встроили в ДНК обычной бактерии, и она, как послушный завод, начала производить нам готовые флуоресцентные белки. Красота этого подхода в том, что мы можем получать их в любых количествах, не мучая термофилов.
Новый белок оказался на удивление стабильным и легко кристаллизуется. Для учёных это подарок судьбы: теперь можно изучать структуру растений, грибов и бактерий со сверхвысоким разрешением. Мы сможем буквально увидеть, как клетка живёт и умирает, в мельчайших деталях, которые раньше были скрыты.
Самое захватывающее, что этот миниатюрный «маячок» легко комбинируется с самыми современными микроскопами — конфокальными и широкопольными. Это значит, что в ближайшие годы нас ждут тысячи новых экспериментов, которые откроют нам глаза на то, как устроена жизнь на самом фундаментальном уровне. Согласитесь, есть за чем понаблюдать?




















































